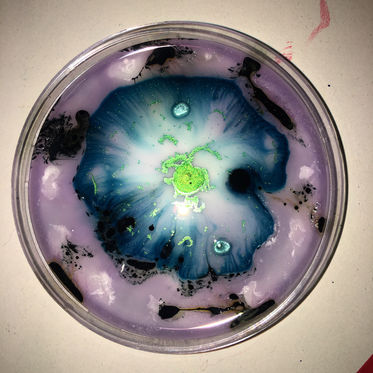
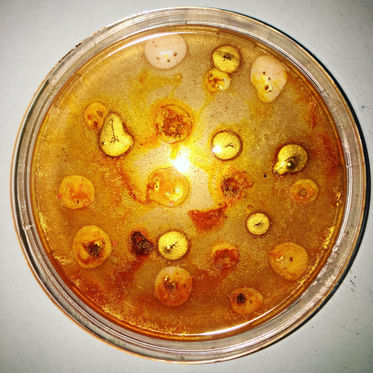

top of page

FLUID ART PROJECT BA (2018)
This project was my first independent project, in the introductory year of my Fine Art course. The project brief was titled "actions". I chose to use paint particularly in textural way rather than just paint on paper. Below you can see the project development and how I explored the actions between paint, canvas and other materials.
ALCOHOL INK STUDIES
INK STUDIES
OIL, INK RESPONSES
CANVASES
PERSPEX
CUPS
PETRI DISHES
PROJECTIONS OF WORK

bottom of page